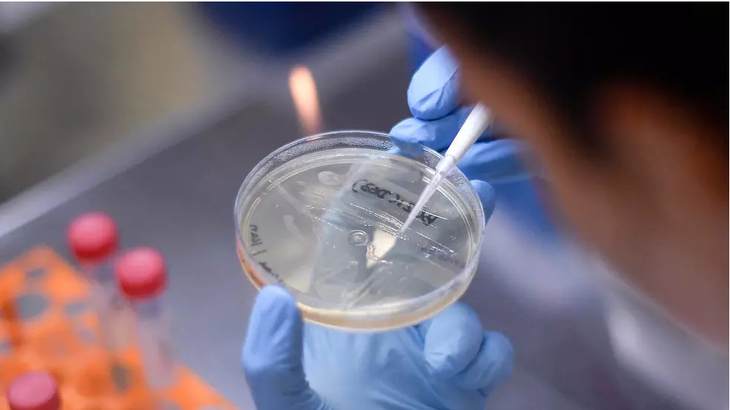
ต้องพยายามร่วมมือในระดับโลกในการผลิตวัคซีนโควิด-19 - ảnh 2

ต้องพยายามร่วมมือในระดับโลกในการผลิตวัคซีนโควิด-19
Huyền -
(VOVWORLD) - ในสภาวการณ์ที่โรคโควิด-19 ยังคงแพร่ระบาดอย่างรุนแรงในทั่วโลก โดยเฉพาะในยุโรป หลายประเทศกำลังพยายามแสวงหายารักษาและการผลิตวัคซีนป้องกันโรคโควิด-19 คือสิ่งที่กำลังได้รับความสนใจเป็นอันดับต้นๆเพื่อขัดขวางการแพร่ระบาดและลดจำนวนผู้เสียชีวิต แต่อย่างไรก็ตาม ประเทศต่างๆต้องใช้ความพยายามร่วมกันในระดับโลกในการผลิตวัคซีนโควิด-19 โดยเร็วที่สุด แทนการแข่งขันระหว่างประเทศต่างๆ
ความพยายามผลิตวัคซีน
ในเวลาที่ผ่านมา ประเทศต่างๆได้ประกาศผลการวิจัยอย่างต่อเนื่องเกี่ยวกับการสร้างพื้นฐานที่สำคัญให้แก่การผลิตวัคซีน เช่นการจัดทำระบบเพาะเชื้อไวรัสในห้องปฏิบัติการ การถอดรหัสจีโนมทั้งหมดของไวรัสและทำความเข้าใจโครงสร้างโมเลกุลของไวรัสนี้อย่างละเอียด
ขณะนี้ วัคซีนป้องกันไวรัส SARS-CoV-2 ยังคงได้รับความสนใจเป็นอันดับต้นๆเพื่อพัฒนาอย่างรวดเร็วจากกลุ่มต่างๆในโลก โดยเมื่อวันที่ 2 เมษายน สำนักงานวิจัยวิทยาศาสตร์และอุตสาหกรรมออสเตรเลียได้เริ่มทดสอบใช้วัคซีนระยะ 1 ในเฟอร์เร็ต 2 ตัวในห้องปฏิบัติการสัตวแพทย์ในเมือง Geelong รัฐวิกตอเรีย ซึ่งมีความหมายสำคัญในการแข่งขันหาวัคซีนป้องกันโรคโควิด-19 ในโลก การทดลองวัคซีนในสัตว์จะเป็นพื้นฐานและความเชื่อมั่นให้แก่นักวิทยาศาสตร์ก่อนทดสอบในคน
บริษัทผลิตยา ชีวภาพ AnGes Inc ของญี่ปุ่นและมหาวิทยาลัยโอซากะได้ยื่นจดสิทธิบัตรผลิตวัคซีนป้องกันโรคโควิด-19 ขณะนี้ บรรดานักวิทยาศาสตร์ของบริษัท AnGes Inc. และมหาวิทยาลัยโอซากะกำลังทดสอบสารประกอบวัคซีนเหล่านี้ในสัตว์ ในขณะเดียวกัน บริษัทบุหรี่ British American Tobacco ประกาศว่า โรงงานวิจัยเทคโนโลยีชีวภาพของบริษัทฯในสหรัฐกำลังพัฒนาวัคซีนโดยใช้โปรตีนสกัดจากใบยาสูบ ขณะนี้ วัคซีนนี้กำลังอยู่ในระยะทดสอบทางคลินิก คาดว่า ตั้งแต่เดือนมิถุนายนนี้จะสามารถผลิตวัคซีนได้ 1-3 ล้านโดสต่อสัปดาห์ภายใต้การสนับสนุนจากภาครัฐและบริษัทที่เกี่ยวข้อง
ห้องปฏิบัติการในบราซิล (AFP) ห้องปฏิบัติการในบราซิล (AFP) |
ต้องใช้ความพยายามในทั่วโลกในการผลิตวัคซีน
ตามความเห็นของบรรดาผู้เชี่ยวชาญด้านสาธารณสุข โดยทั่วไปการวิจัยและพัฒนา วัคซีนต้องได้รับการทดสอบในสัตว์ก่อนทดสอบในคน และต้องใช้เวลาอีกประมาณ 6-36 เดือนเพื่อผลิต แต่สำหรับไวรัสที่ซับซ้อนเช่น SARS-CoV-2 อาจใช้เวลานานกว่า ซึ่งในสภาวการณ์ที่จำนวนผู้เสียชีวิตจากไวรัสนี้ในทั่วโลกกำลังเพิ่มขึ้นอย่างรวดเร็ว ทำให้เกิดแรงกดดันเป็นอย่างมากต่อนักวิทยาศาสตร์ในทั่วโลกในการหาทางผลิตวัคซีน
การพัฒนาวัคซีนที่มีศักยภาพต่อต้านโรคโควิด-19 กำลังบรรลุความคืบหน้าอย่างรวดเร็ว แต่องค์การอนามัยโลกหรือ WHO เตือนว่า การที่ประเทศต่างๆแข่งขันเพื่อพัฒนาวัคซีนโดยไม่มีความร่วมมือในระดับโลกอาจนำไปสู่การผลิตวัคซีนที่ไม่ปลอดภัยและมีเวลาทดสอบไม่เพียงพอ ซึ่งสิ่งนี้อันตรายมาก เพราะวัคซีนอาจจะทำให้โรคโควิด-19 แพร่ระบาดรวดเร็วมากขึ้นหรือก่อให้เกิดโรคแทรกซ้อน โดยเฉพาะทำให้ระบบภูมิคุ้มกันอ่อนแอลง นอกจากนั้น เมื่อวัคซีนได้รับการทดสอบจนเห็นว่า มีความปลอดภัยและมีประสิทธิภาพ ก็ต้องลงทุนโครงสร้างพื้นฐานเพื่อจำหน่ายวัคซีนในระดับโลกบนพื้นฐานแห่งความเสมอภาค ประเทศต่างๆต้องมีคำมั่นทางการเมืองเพื่อค้ำประกันว่า ทุกประเทศสามารถเข้าถึงและตอบสนองความต้องการใช้วัคซีนและยารักษาโรคโควิด-19 ได้ถ้าหากวิจัยสำเร็จ
ขณะนี้ มีสัญญาณที่น่ายินดีคือองค์การพหุภาคีได้รับการสนับสนุนจากรัฐบาลต่างๆ บริษัทเภสัชกรรมและผู้ที่มีใจกุศลพร้อมสนับสนุนเงินนับร้อยล้านดอลลาร์สหรัฐในการพยายามผลิตวัคซีน โรคโควิด-19 ยังคงแพร่ระบาดอย่างรุนแรงในโลกและส่งผลกระทบอย่างหนักและไม่สามารถคาดการณ์ได้ เพื่อผลักดันกระบวนการผลิตและจำหน่ายวัคซีนอย่างกว้างขวาง ต้องมีความพยายามในระดับโลกแทนการแข่งขันเพื่อผูกขาดของแต่ละประเทศ./.
Huyền